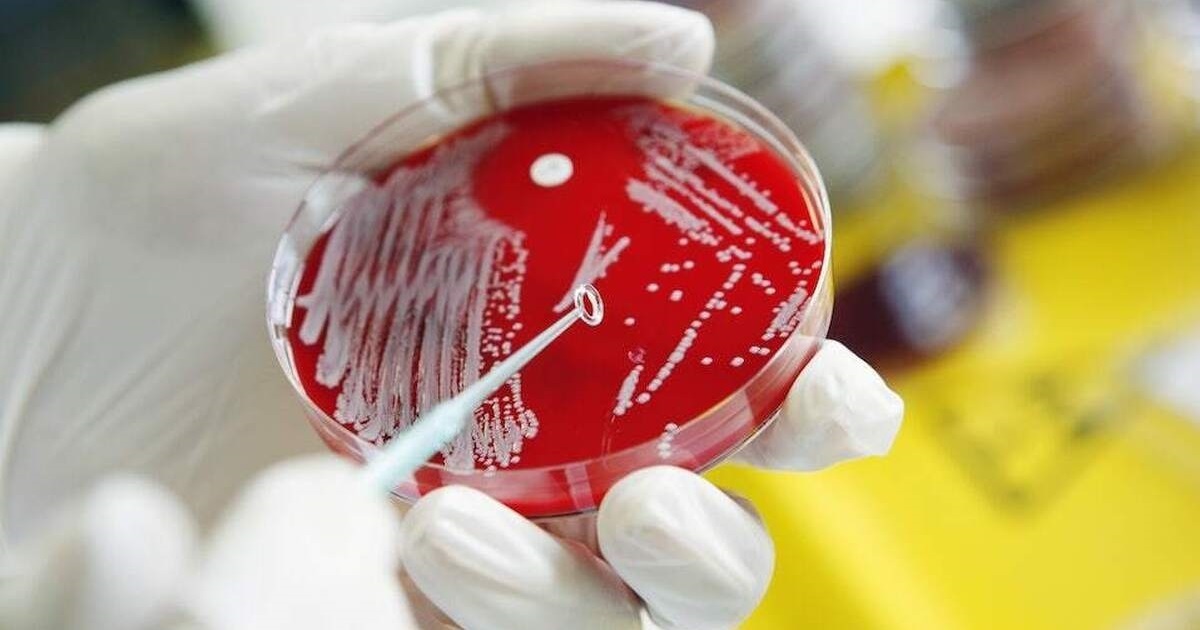

چگونه میکروبها تاریخ را رقم زدند؟
شیوع بیماری ها ممکن است در مقایسه با اقدامات و برنامه های انسانی تاثیر بیشتری بر روند رویدادها داشته باشند. کندی در کتاب "پاتوژنز" اشاره می کند که سیر تاریخ کم تر به میل ما مربوط می شود و بیش تر مرتبط با شیوه های بروز بیماری های مختلف در آب و هوای گوناگون است.
دست راستی های اونجلیکال (انجیلی) همواره منتظر آخرالزمان هستند. آنان روزشماری می کنند و نشانه ها و شگفتی هایی را ترسیم می کنند و در مورد زمان و ساعت آخرالزمان به محاسبه می پردازند. می توان تصور کرد که در سال 2020 میلادی زمانی که جهان با یک فاجعه جهانی و از هم گسیختگی کامل در نظم عادی امور مواجه شد آنان کووید – 19 را به عنوان نشانه ای مطمئن و قطعی از فرا رسیدن آن روز قلمداد کردند. با این وجود، آنان در اغلب موارد به جای پذیرش ویروس کرونا آن را انکار کردند: رئیس جمهور وقت امریکا و کشیش های نزدیک به او شدت و تاثیر کووید را کم اهمیت جلوه دادند و مدعی شدند که آمار و ارقام مرتبط با تعداد افرادی که جان شان را بر اثر ابتلا به آن ویروس از دست داده اند اغراق آمیز بوده و کسانی که این موضوع را جدی می گرفتند مورد تمسخر قرار می دادند. آنان به جای آن که آخرالزمان فرضی شان را در آغوش بگیرند خواستار بازگشت به وضعیت پیش از آن شدند.
به گزارش فرارو به نقل از نیوریپابلیک، شاید این موضوع به درکی مربوط باشد که بسیاری از ما در ماه های ابتدایی سال 2020 میلادی از رخدادها داشتیم: ما به طور ناگهانی و بنیادی با شرایط ویروس و نه با شرایط خود زندگی می کردیم. به جای نبرد بزرگ خیر و شر با انسان ها ما موظف بودیم درباره موجودی غیرانسانی که انگیزه و هدف اش برای مان غیر قابل درک بود بیش تر بیاموزیم و رفتار خود را با آن انطباق دهیم.
"جاناتان کندی" متخصص بهداشت عمومی در کتاب خود تحت عنوان "پاتوژنز (بیماری زایی): چگونه میکروبها تاریخ را ساخته اند"؟ از ما می خواهد در مورد رابطه خود با باکتری ها و ویروس ها که باعث بروز پاندمی ها می شوند تجدیدنظر کنیم. کندی می گوید شاید ما قهرمان داستان خود نباشیم. شاید ما صرفا بازیگران کوچکی در یک درام بزرگتر هستیم. او داستان تمدن بشری را از اولین ریشه های ماقبل تاریخ تا دهه کنونی بازگو می کند اما این کار را از منظر انسان های بزرگ انجام نمی دهد بلکه با نگاه به بیماری های بزرگ و باکتری های و ویروس هایی که از زمان ظهور هوموساپینس (انسان خردمند) به عنوان یک گونه ما را تحت تاثیر قرار داده اند، انجام داده است. از دید کندی آبله، تب زرد و مالاریا بسیار مهم تر از شارلمانی (امپراتور رومیان و عامل اتحاد اکثر بخش های اروپای غربی و مرکزی)، کورتس (سردار اسپانیایی فاتح امپراتوری آزتک در قاره امریکا) یا ناپلئون بوده اند. او نه تنها استدلال می کند که "انسان ها جایگاه بسیار کم تری در جهان نسبت به آن چه پیش تر فکر می کردیم" دارند بلکه "میکروب ها نقش بسیار مهم تری نسبت به آن چه که چند سال پیش فکر می کردیم ایفا می کنند".
کندی به نقل از "استفن جی گولد" که نوشته بود "با هر معیار ممکن، معقول یا منصفانه باکتری ها شکل غالب زندگی روی زمین هستند و همیشه بوده اند" استدلال می کند که ما به همان اندازه که محصول هر تصمیم آگاهانه ای هستیم محصول بیماری می باشیم. او در مقدمه کتاب خود می نویسد:" شیوع بیماری های عفونی میلیون ها زندگی را از بین برده و تمدن های کامل را نابود کرده اما این ویرانی فرصت هایی را برای جوامع و ایده های جدید فراهم ساخته تا رشد کنند. بدین ترتیب، عوامل بیماری زا در بسیاری از مهم ترین دگرگونی های اجتماعی، سیاسی و اقتصادی تاریخ نقش آفرینی کرده اند".
در اینجا یک ایده رادیکال مطرح می شود: اگر ما با تمام امیدها، رویاها و بهترین نقشه های مان چیزی جز مواد خامی نباشیم که توسط باکتری ها و ویروس ها برای شکل دادن به تصویرشان از جهان مورد استفاده قرار می گیریم چه می شود؟!
کندی این استدلال را از طریق قالب بندی مجدد وقایع تاریخی شناخته شده از نظر بیماری ها و اپیدمی هایی که منجر به آن شده مطرح می کند. ظهور و سقوط امپراتوری ها، فتوحات وحشیانه قدرت های استعماری و نقشه ای که اکنون می شناسیم تمام این موارد بیش از آن چه فکر می کردیم به بیماری بستگی داشته اند.
برخی از این موارد ممکن است آشنا به نظر برسند: برای مثال، این واقعیت که مهاجران اروپایی در آمریکای شمالی عمدا و ناخواسته از آبله برای از بین بردن جمعیتهای بومی استفاده کردند تا روند استعمار تسهیل شود. به قول کندی آبله که در آمریکای شمالی کاملا جدید بود از اسپانیاییها جلوتر بود و کل جوامع را ویران کرد. این بیماری تعیین کننده بود. او استدلال می کند که تلاش های اولیه برای استعمار سرزمین اصلی آمریکا بدون کمک پاتوژن های دنیای قدیم پایه گذاری شد. برای مثال، تلاش فاتحان اسپانیایی برای تصرف تنوچتیتلان را در نظر بگیرید. اولین تلاش آنان با شکست همراه بود اما نیروی اعزامی دوم که یک سال بعد به آنجا وارد شد آبله را با خود آورد امری که باعث ویرانی شهر شد و پیروزی را برای اسپانیا به ارمغان آورد.
ورود پیوریتن ها و سکونت در مستعمره پلیموث (در ماساچوست امروزی) رخدادی ظریف تر بود. تلاش های قبلی برای ایجاد مستعمرات در نیوانگلند با مقاومت شدید مردم بومی که پیش تر در آنجا زندگی می کردند مواجه شده بود. مستعمره پوفام در جنوب ایالت مین پس از 14 ماه متحمل شکست شد. پست تجاری فرانسه در نزدیکی کیپ کاد نیز در معرض حملات بومیان قرار گرفت. با این وجود، تلاش های قبلی با گسترش بیماری زمینه را برای پیوریتن ها فراهم ساخت. زمانی که زائران به آنجا رسیدند دهکده های متروکه ای با غلات و حبوبات را یافتند که برای گذراندن اولین زمستان خود از آن استفاده می کردند. بقایای جوامع بومی توسط آبله ویران شده بودند. در حالی که این اروپاییها آن مواد غذایی را "مشیت خوب" خداوند قلمداد می کردند کندی در کتاب اش اشاره می کند که آنان بایستی در روز شکرگزاری از عوامل بیماری زای دنیای قدیم قدردانی می کردند که اسکان مستعمره پلیموث را امکان پذیر ساختند. به طور اساسی در روایت کندی از رخدادها استعمارگر واقعی قاره آمریکا ویروس واریولا بود که اسپانیایی ها و بریتانیایی ها صرفا میزبانان ناخواسته آن بودند.
نمونه های دیگری که کندی به آن اشاره می کند ممکن است تعجب آورتر باشند. او توضیح میدهد که علیرغم وجود قنات ها و سیستم های فاضلاب پرافتخار امپراتوری روم عدم درک رومی ها از میکروب به این معنی است که زیرساختهای آبی آنان دچار بیماری زایی شده و سقوط امپراتوری را سرعت بخشیده بود. کندی با استناد به کتاب "سرنوشت روم" اثر "کایل هارپر" استدلال میکند که پاندمی ها آسیب عظیمی به بار آوردند و نقش مهمی در تضعیف امپراتوری روم ایفا کردند نقشی به مراتب بزرگتر از اقدامات بربرها در دروازه های شهر.
هم چنین، کندی در کتاب "پاتوژنز" به طور قانع کننده ای استدلال می کند که تولد کشور هائیتی و شاید حتی ظهور ایالات متخده در شکل کنونی آن را بتوان با دنبال کردن شیوع تب زرد از طریق پشه تب زرد (Aedes aegypti) به عنوان میزبان اصلی آن ردیابی کرد.
در سال 1802 میلادی حدود یک دهه پس از وقوع انقلاب هائیتی ناپلئون یک نیروی اعزامی متشکل از 30000 سرباز را به سن دومینیک مستعمره سابق خود به امید بازپس گیری سرزمین و تحمیل مجدد برده داری اعزام کرد. با این وجود، جمعیت آزاد شده هائیتی نه با قدرت نظامی بلکه با بیماری آنان را شکست دادند. همان طور که "ژان ژاک دسالین" از رهبران انقلاب هائیتی و اولین حاکم هائیتی مستقل براساس قانون اساسی 1805 میلادی در مارس 1802 میلادی به سربازان تحت امرش گفت:"سفید پوستان از فرانسه نمی توانند در اینجا در سن دومینیک علیه ما مقاومت کنند. آنان ابتدا خوب می جنگند اما به زودی بیمار شده و مانند مگس می میرند".
ارتش تحت امر دسالین از تب زرد جزیره علیه فرانسویان مهاجم استفاده کرد. هنگامی که نیروهای ناپلئون برای اولین بار در بهار وارد شدند از یک درگیری مستقیم جلوگیری کرد و آنان را به باتلاق کشاند که تا تابستان زمانی که باران بارید ادامه داشت. با بارش باران آب راکد شرایط مناسبی را برای رشد و پرورش پشه حامل تب زرد فراهم ساخت و برای دسالین به به متحدی حیاتی در برابر نیروهای فرانسوی تبدیل شد. طبق تخمین های صورت گرفته از سوی یکی از مورخان از 65 هزار سرباز فرانسوی که برای بازپس گیری مستعمره اعزام شده بودند 50 هزار نفر جان خود را از دست دادند که اکثرا بر اثر ابتلا به تب زرد فوت کرده بودند.
فرانسویانی که قادر به حفظ مقرهای دور افتاده خود در دریای کارائیب نبودند در نهایت قلمروی وسیع لوئیزیانا را به ایالات متحده فروختند. این واقعیتی است که باعث می شود کندی نتیجه گیری کند ایالات متحده آن گونه که امروز وجود دارد مدیون جمعیت پشه های هائیتی است.
کندی در کتاب "پاتوژنز" اشاره می کند که سیر تاریخ کم تر به میل ما مربوط می شود و بیش تر مرتبط با شیوه های بروز بیماری های مختلف در آب و هوای گوناگون است.
در مکان هایی که اروپایی ها کمتر مستعد ابتلا به بیماری بودند مانند آمریکای شمالی استعمارگران خانواده هایی را تشکیل دادند و شهرک هایی ایجاد کردند که در نهایت به دموکراسی های ثروتمند تبدیل شدند.
در نقاطی مانند جنوب صحرای آفریقا که اروپایی ها بیش تر مستعد ابتلا به عوامل بیماری زا بودند آنان صنایع درنده و استخراجی را راه اندازی کردند تا با حداقل قرار گرفتن در معرض محیط زیست سودی حداکثری را کسب کنند مردان اعزام شده به آنجا پیش از آن که سالم و ثروتمند نزد خانواده های شان در اروپا بازگردند هر آن چه را که می توانستند غارت کردند. آن چه آنان پشت سر گذاشتند مناظر مملو از منابع طبیعی و کشورهایی بود که ده ها سال پس از آن هنوز برای دستیابی به هر نوع برابری اقتصادی دوردست با قدرت های استعماری سابق تلاش می کنند.
گاهی اوقات به نظر می رسد این استدلالی ضعیف است.
کندی اشاره می کند در دوره های دیگر پاندمی ها به عنوان کلیدی در پشت کل تاریخ بشر بدان معناست که کتاب پاتوژنز احتمالا به قلمروی مشابه کتاب هایی چون "انسان خردمند" نوشته "یووال نوح هراری" و "اینک روشنگری: پرونده ای درباره عقل، علم، انسان گرایی و پیشرفت" نوشته "استیون پینکر" لغزیده باشد کتاب هایی که با در نظر گرفتن یک فرضیه و استدلال خاص سعی می کنند کل تاریخ بشر را توضیح دهند.
با این وجود، این موضوع از اهمیت ایده اصلی کتاب "پاتوژنز" نمی کاهد. آن چه آن کتاب آشکار می سازد این حقیقت آشکار است که انسان ها برخلاف آن چه پیش تر تصور می کردیم اغلب تنها بازیگران صحنه بزرگ تاریخ نیستند و نکته مهم تر آن است که ممکن است مهم ترین بازیگران تاریخ نیز نبوده باشیم. ما به قدری از بیماری ها استفاده کرده ایم و توسط بیماری ها مورد استفاده قرار گرفته ایم که در بخش پایانی کتاب کندی خواننده با تعجب از خود می پرسد آیا ممکن است ما اساسا برای انتشار موجوات میکروسکوپی و ویروس ها وجود داشته باشیم؟!
در نتیجه پاتوژن ها به همان اندازه که ما به آن ها نیاز داریم به ما نیاز دارند. داستان در اینجا مربوط به وابستگی متقابل ما و میکروب های درون ما به یکدیگر است. تاثیر واقعی پاتوژنز نوشته کندی به جای نشان دادن آن که انسان ها تا چه اندازه در طرح بزرگ جهان بی اهمیت هستند ممکن است دعوت از ما برای بازنگری بیش تر در مورد این تصور اشتباه دوگانه طولانی مدت از خود باشد تصوری که تلاش می کند انسان را از سایر موجودات زنده روی سیاره زمین جدا سازد.
هم چنین، آن کتاب کمک می کند تا تحولات چند سال اخیر را در بستری بزرگ تر ببینیم. اگر تاریخ بشر را کم و بیش به طور دائمی درگیر یک پویایی پیچیده با میکروب ها ایجاد پاندمی ها و واکنش به آن بدانیم در نتیجه شیوع کووید – 19 را کم تر منادی آخرالزمان قلمداد کرده و در عوض تازه ترین رویدادی خواهیم دانست که در آن انسان ها میزبان یک بازیگر دیگر در عرصه جهانی بوده اند.
لینک کوتاه: کپی لینک
اطلاعیه جدید ستاد پرداخت به بازماندگان سانحه پرواز ۷۵۲ اوکراین صادر شد مدیر جدید شبکه افق معرفی شد درگیری تام کروز و برد پیت و یک ویدیوی جعلی ؛ آیندهای نگرانکننده برای سینما 10 نکته دربارۀ حقوق هزار دلاری رییس جمهوری و مقایسه با 25 سال قبل کویینسی: آمریکایی ها جنگ با ایران را نمیخواهند درخشش غیرمنتظره مهاجم سابق پرسپولیس؛ شرزود تمیروف در صدر گلزنان لیگ عراق پدر امباپه: کیلیان در ۱۳ سالگی خانه را ترک کرد پوتین سالگرد پیروزی انقلاب اسلامی را تبریک گفت معجزه علیرضا منصوریان در عراق؛ الطلبه مدعی جدید قهرمانی سنگینترین شکست ۲۱ سال اخیر هانسی فلیک مقابل اتلتیکو خبر مهم مجلس برای بازنشستگان ریزش همزمان دلار و سکه؛ بازارها در فاز اصلاح یا آرامش موقت؟ پیش بینی شما از نتیجه مذاکرات ایران و آمریکا طی یک ماه آتی؟ (نظرسنجی جدید عصر ایران) شکست پرسپولیس در نیمه اول مقابل گلگهر با گلهای تماشایی صعود فولاد سیرجان به پلیآف لیگ برتر والیبال علیرغم شکست
نظرسنجی
پیش بینی شما از نتیجه مذاکرات ایران و آمریکا طی یک ماه آتی؟

.png)


